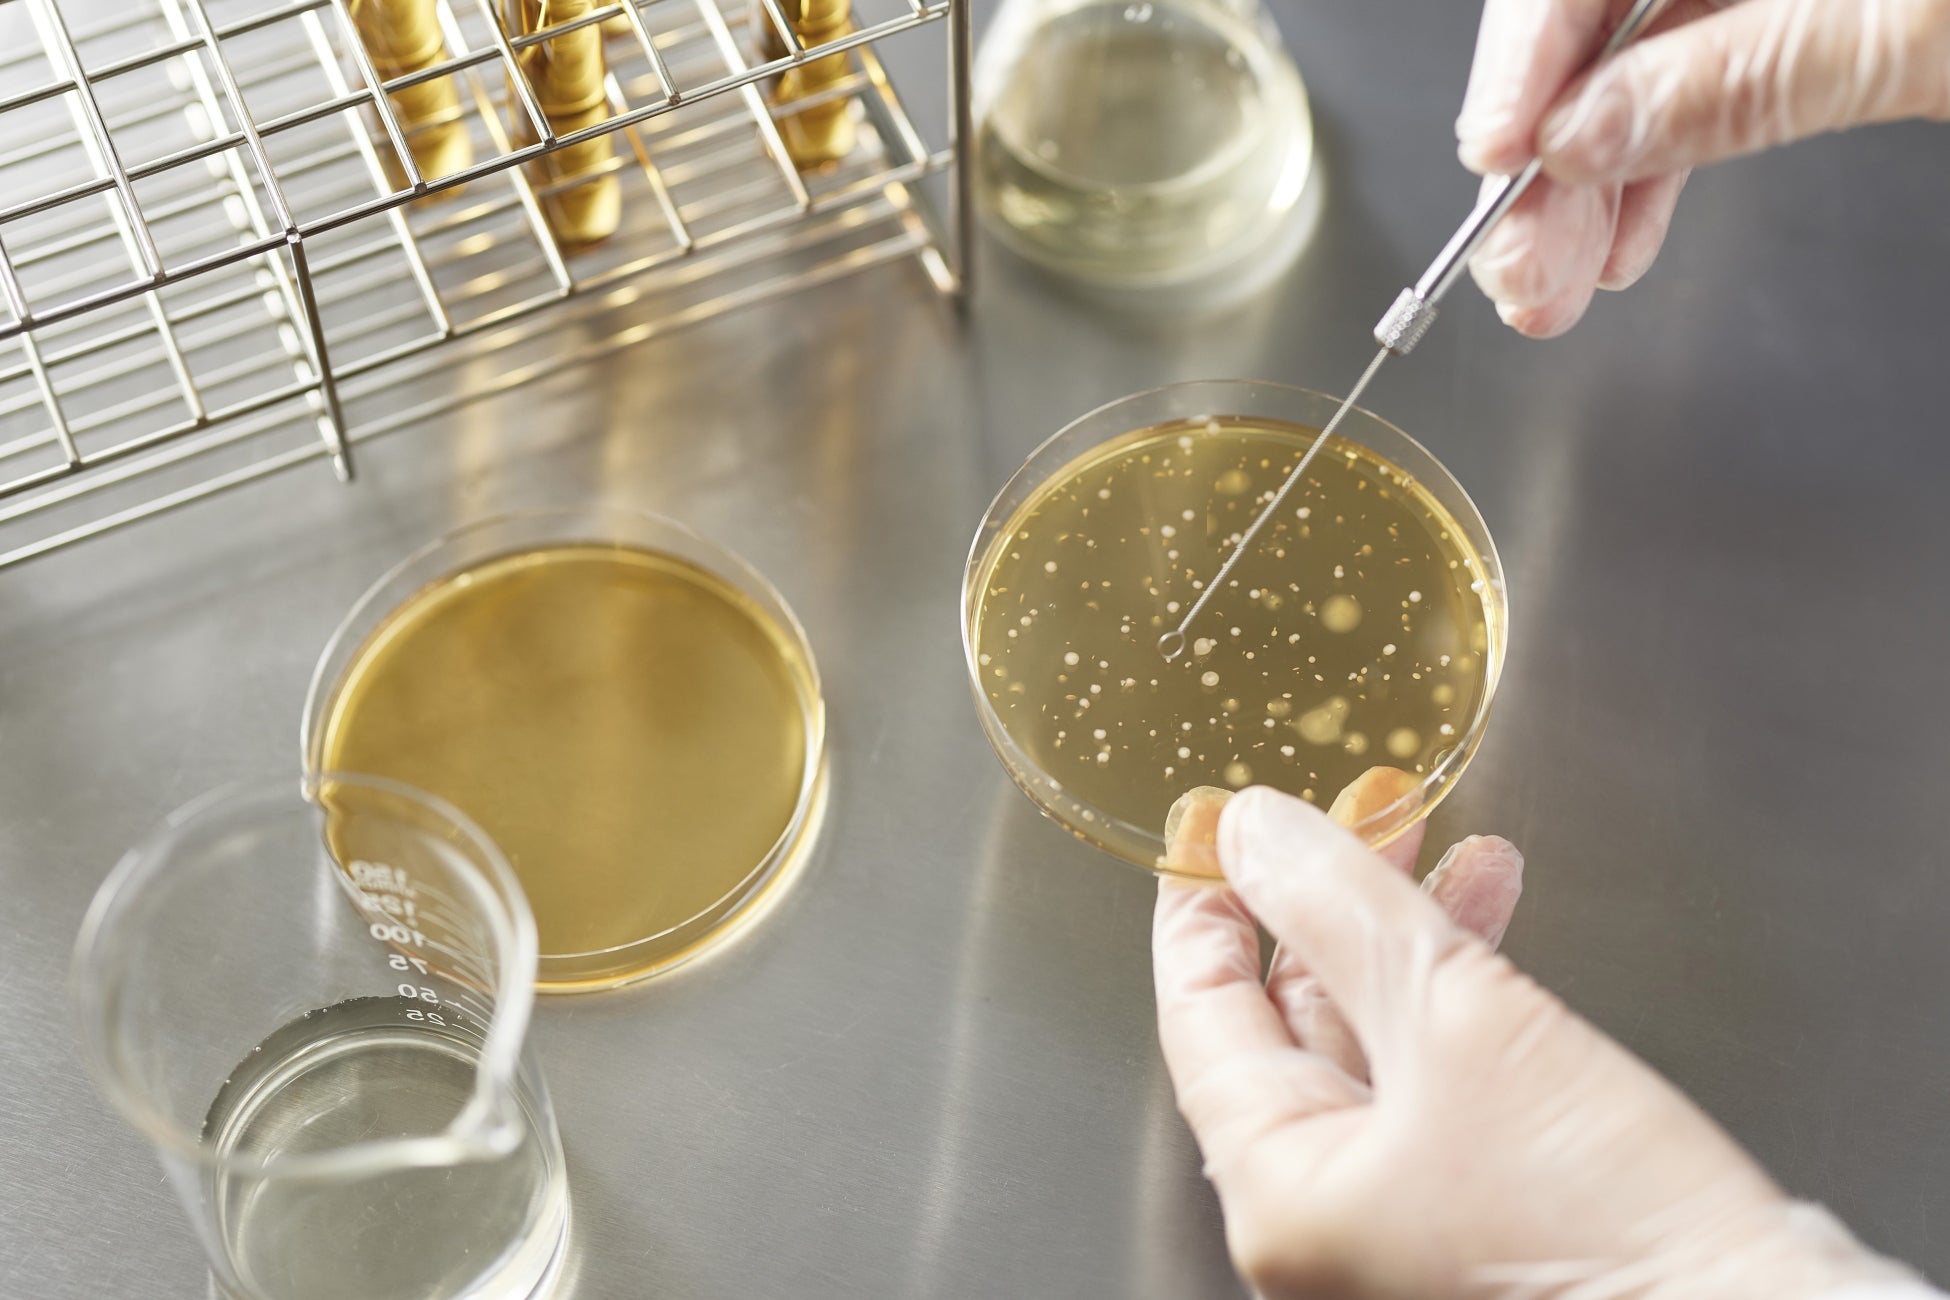

[注目のマイクロバイオームケア]メゾンレクシア研究チームが独自開発に成功、2つのバイオティクス成分誕生
稀少植物の栽培・保護と技術開発力で独自処方を究めるメゾンレクシアは、肌の健康・美しさの鍵を握るマイクロバイオーム(肌表面のバリア機能を司る常在菌の集合体)に着目し、一人ひとり異なる多様なマイクロバイオームを、美しい肌を保つのに理想的なバランスに整える、従来の肌ケアとは異なる“パーソナライズド菌ケア”の研究を、2022年よりスタートいたしました。
そして東京農業大学 生命科学部 分子微生物学科 田中尚人教授の指導のもと、北海道の自社農園で育てる絶滅危惧植物ヤチヤナギの葉から、新たに〈ヤチヤナギ乳酸菌〉を採取することに成功。この植物性乳酸菌を使い、すこやかな肌環境に有益なポストバイオティクス成分である「ヤチヤナギ乳酸菌培養液(※1)」を独自開発。さらに美肌菌(肌に常在する善玉菌)を活性化させるプレバイオティクス成分である「フェイスバランスコンプレックス(※2)」も開発いたしました。
2つの新成分には、従来から着目されている美容成分も豊富に含まれるため、高いエイジングケア(※3)効果も期待されます。メゾンレクシアは今後この独自成分を活かし、善玉菌とともに人々がすこやかに美しく生きるための新製品を展開してまいります。




肌の健康・美しさの鍵を握るマイクロバイオーム
腸の内側や頭皮・顔・体の皮膚表面にも。人の体には善玉菌や悪玉菌など、多種多様な菌が存在しています。菌の種類と量、バランスは人によって異なり、DNAや指紋のように千差万別。そしてこのマイクロバイオーム(常在菌の集合体)の量やバランスが、人の腸内はもちろん肌の健康状態や美しさにも大きな影響を与えることが、近年明らかになっています。

期待が高まる「ポストバイオティクス」アプローチ
現在マイクロバイオーム研究には、主に3つのアプローチがあります。とくに2021年に定義(※4)された「ポストバイオティクス」は、乳酸菌などの善玉菌がエサを食べることで代謝する人体に有用な成分に着目し活用する研究。免疫力の活性化はもちろん肌のバリア機能アップなどの高い美肌効果が期待されています。

メゾンレクシアも今回「ポストバイオティクス」と「プレバイオティクス」に着目。約3年の歳月をかけて新成分を開発しました。
[New ポストバイオティクス成分]
自社農園で育てる稀少植物から開発「ヤチヤナギ乳酸菌培養液(※1) 」
ヤチヤナギ乳酸菌由来の、美肌に有用な成分が約37億個*
自社農園のヤチヤナギの葉から採取した独自の自社菌株“ヤチヤナギ乳酸菌”の培養液。乳酸や20種のアミノ酸、4種のビタミンB類、ぺプチド類、ポリフェノール類といった美容成分を豊富に含み、浸透性と 保湿性にすぐれたポストバイオティクス成分です。ゲノム解析では抗菌物質を産生できる可能性も示唆されており、さらなる美肌効果が期待されています。
[主な美容成分]
・乳酸: マイルドなピーリング効果で、肌のターンオーバーをサポート
・アミノ酸: NMFの約60%を占め、肌を保湿しキメを整える
・ビタミンB類(B3・B5・B6・B7): 肌あれ防止、シワ・シミ改善
・ペプチド類: アミノ酸の結合物。肌のハリ感・弾力をアップ
・ポリフェノール類: 高い抗酸化・抗炎症作用がある
*ヤチヤナギ乳酸菌培養液(※1)原液1mL当たりの含有菌数、自社調べ
多彩な美容成分によるエイジングケア(※5)&ブライトニングケア(※6)効果も実証*
加齢により減少しがちな美容成分を豊富に含むことで、シワ・シミ生成を加速させるマイナス要素と戦います。


[New プレバイオティクス成分]
200万通り以上の調合研究から誕生「フェイスバランスコンプレックス(※2)」
メゾンレクシアで抽出したパワフルな植物エキス5種の複合成分(※2)。自社エキス約50種・200万通り以上の膨大な組み合わせから、顔の皮膚常在菌に対して効果的に働く5種類を厳選。個々の特性を生かし美肌菌(善玉菌である表皮ブドウ球菌) のみを増やし、悪玉菌(黄色ブドウ球菌)を抑制することが可能な、黄金比率で調合しています。



2つの新成分の相乗効果で、善玉菌は133%増、悪玉菌は65%減*
2つの新成分を組み合わせることで、善玉菌は133%増加、悪玉菌は65%減少することが確認されました*。メゾンレクシアは今後もバイオティクス成分開発をさらに究め、菌とともに人々がすこやかに美しく生きるための新製品を展開してまいります。
*エキス無しと比較した菌数、自社調べ
※1.ペディオコッカス培養溶解質(整肌成分) ※2.セイヨウハッカ葉エキス、オトギリソウエキス、サンザシエキス、トウキンセンカエキス、クマザサエキス(整肌成分) ※3.年齢に応じたお手入れ ※4. 2021年に国際プロバイオティクス・プレバイオティクス科学協会(ISAPP)が提唱 ※5.年齢に応じたお手入れ ※6.透明感を与える

植物 × サイエンスの力で、ウェルネスビューティーを叶える
2001年、日本発祥のメゾンレクシア。北海道の自社ファームで育てる絶滅危惧植物やハーブから抽出する栄養豊富なエキスやオイル、植物とサイエンスを融合させた独自の美容成分。自然のパワーとこだわりをふんだんに詰め込み、本来、人に備わったすこやかな機能を目覚めさせるようホリスティックにアプローチ。日々の揺らぎも、年齢に応じた本格的なケアも。それぞれの年代を美しく生きる、肌・体・心のウェルネスビューティーを植物の力で叶えます。
【取扱】
・メゾンレクシア直営店(淀屋橋店、阪神梅田本店)
・公式サイト https://maisonlexia.com
このプレスリリースには、メディア関係者向けの情報があります
メディアユーザー登録を行うと、企業担当者の連絡先や、イベント・記者会見の情報など様々な特記情報を閲覧できます。※内容はプレスリリースにより異なります。
すべての画像
